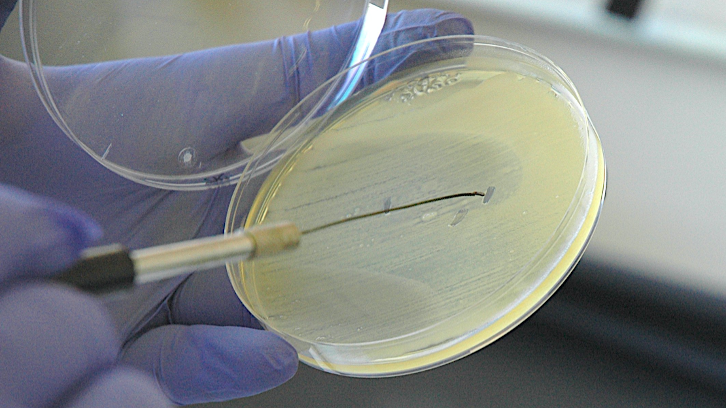
imatge representant de consolidació fòssils bacteris

El oro romano del Pirineo Oriental
Un estudio del Departamento de Ciencias de la Antiguidad y de la Edad Media ha conseguido demostrar la existencia de minas de oro aluvial de época romana en el Pirineo Oriental. Esto ha sido posible gracias a la datación mediante nuevas técnicas de...